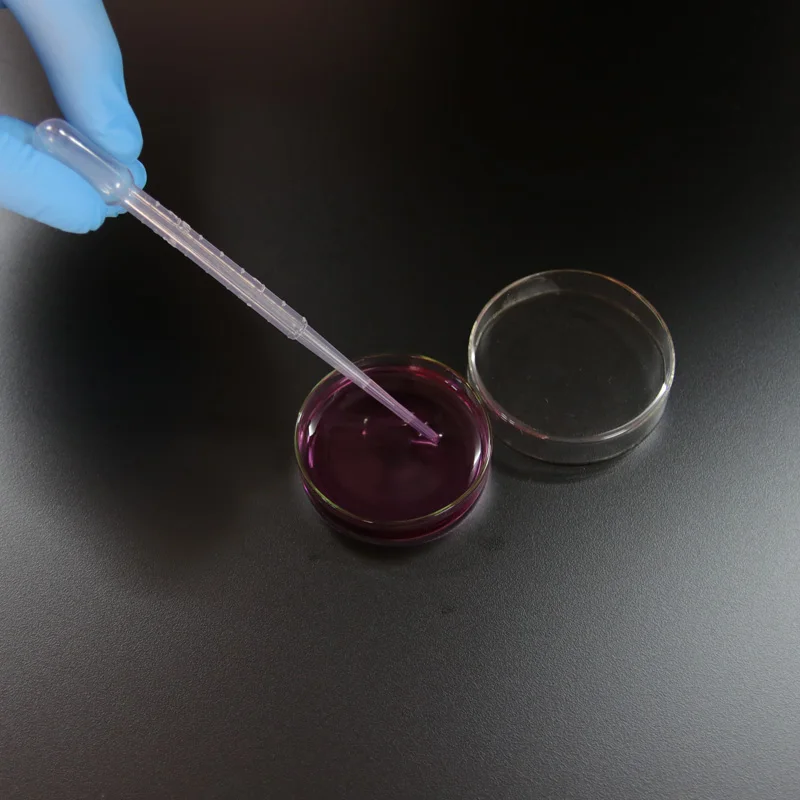
10 шт. 60 мм Стеклянная Чаша Петри лабораторная химическая биология чаша |
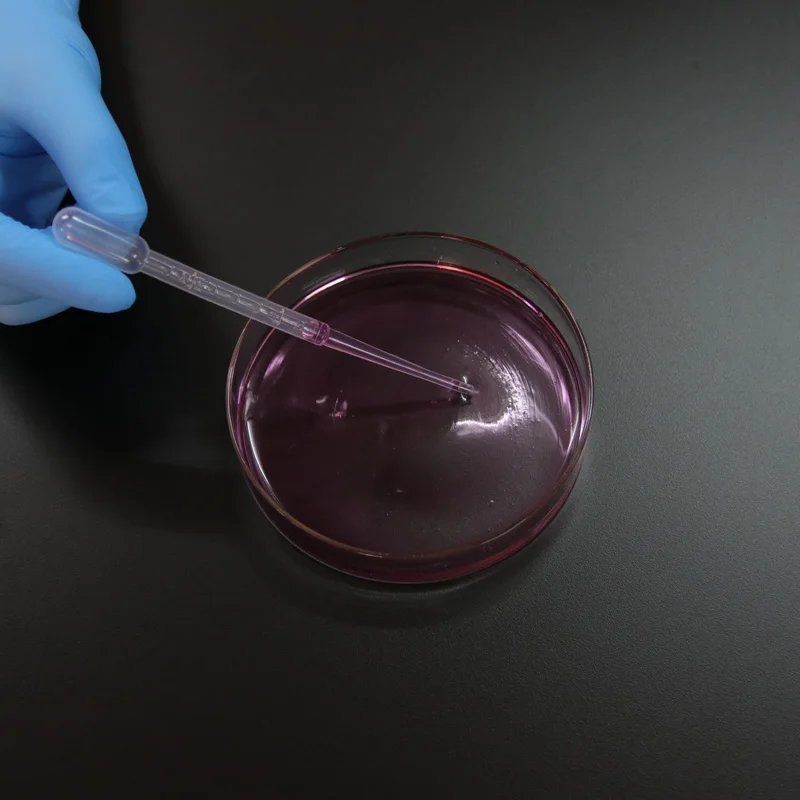
10 шт. 60 мм Стеклянная Чаша Петри лабораторная химическая биология чаша |

10 шт. 60 мм Стеклянная Чаша Петри лабораторная химическая биология чаша |
Сохраните в закладки:






История цены
*История изменения цены! Указанная стоимость возможно, уже изменилось. Проверить текущую цену - >
| Месяц | Минимальная цена | Макс. стоимость | Цена |
|---|---|---|---|
| Feb-20-2026 | 2973.36 руб. | 3032.94 руб. | 3002.5 руб. |
| Jan-20-2026 | 2411.1 руб. | 2459.94 руб. | 2435 руб. |
| Dec-20-2025 | 2926.27 руб. | 2985.41 руб. | 2955.5 руб. |
| Nov-20-2025 | 2903.76 руб. | 2961.30 руб. | 2932 руб. |
| Oct-20-2025 | 2318.94 руб. | 2364.62 руб. | 2341 руб. |
| Sep-20-2025 | 2856.62 руб. | 2913.17 руб. | 2884.5 руб. |
| Aug-20-2025 | 2833.93 руб. | 2890.78 руб. | 2861.5 руб. |
| Jul-20-2025 | 2809.5 руб. | 2865.82 руб. | 2837 руб. |
Новые товары
Ячейка JGS1 кварцевая кювета с пробкой внутренняя ширина 3 мм 1050ul - купить по
Стеклянная многоразовая тарелка Петри для культуры миска с крышкой химической
5 шт. прозрачная стеклянная посуда для лабораторных часов крышка стакана
250 мл фарфоровое Испаряющее блюдо круглое дно химическое покрытие диаметр 111 мм -
SOSW-10 шт 60 мм x 15 полистирол стерилизованные чашки Петри с крышками - купить по
5 шт. стеклянные чаши Петри из боросиликата для выращивания клеток школы - купить
Контактная Пластина Rodac 1000 шт./лот 55 мм для поверхностного микробного отбора проб
FTO покрытое проводящее стекло 50*50*2 2 мм 7-10 Ом/кв 10 шт. лабораторное прозрачное
Характеристики
10 шт. 60 мм Стеклянная Чаша Петри лабораторная химическая биология чаша |
Описание товара
60 мм Стеклянная Чаша Петри
Стеклянные чашки Петри, изготовленные из боросиликатного стекла, С гладкой поверхностью и оптимальным прозрачным корпусом, в основном применяется для научных исследований, биологических экспериментов. И т. д.









Трекер стоимости
Отзывы покупателей
Новые отзывы о товарах
Попросила мужа выбрать себе куртку, ему как всегда некогда этим заниматься, пришлось самой искать. Нашла и заказывала мужу такую толстовку,... Читать отзыв полностью...
Не давно мы с подругой купили джинсы, сначала обе переживали потому что первый раз покупали одежду через интернет. Мы получили... Читать отзыв полностью...
Приятненькая и довольно-таки удобная женская блузка, я на личном примере в этом убедилась) Заказала несколько штук, вот прям все мне... Читать отзыв полностью...
Очень крутые джинсы, отлично сидят на фигурке, лично мне импонирует защитный окрас, ткань не тонкая, достаточно плотная, но при этом... Читать отзыв полностью...
Покупаю не первый раз дочке для садика в этом интернет-магазине хлопковые платья. Очень удобные и красивые, огромные выбор расцветок на... Читать отзыв полностью...
Недавно получила это замечательно платье для своей доченьки и была приятно удавлена.Качество оказалось на уровне, материал приятный к телу,что немаловажно.По... Читать отзыв полностью...

Клёвая футболка, для фанатов Теории Большого Взрыва вообще подойдёт идеально) Да и качество у неё хорошее, ничего не рвётся, не... Читать отзыв полностью...